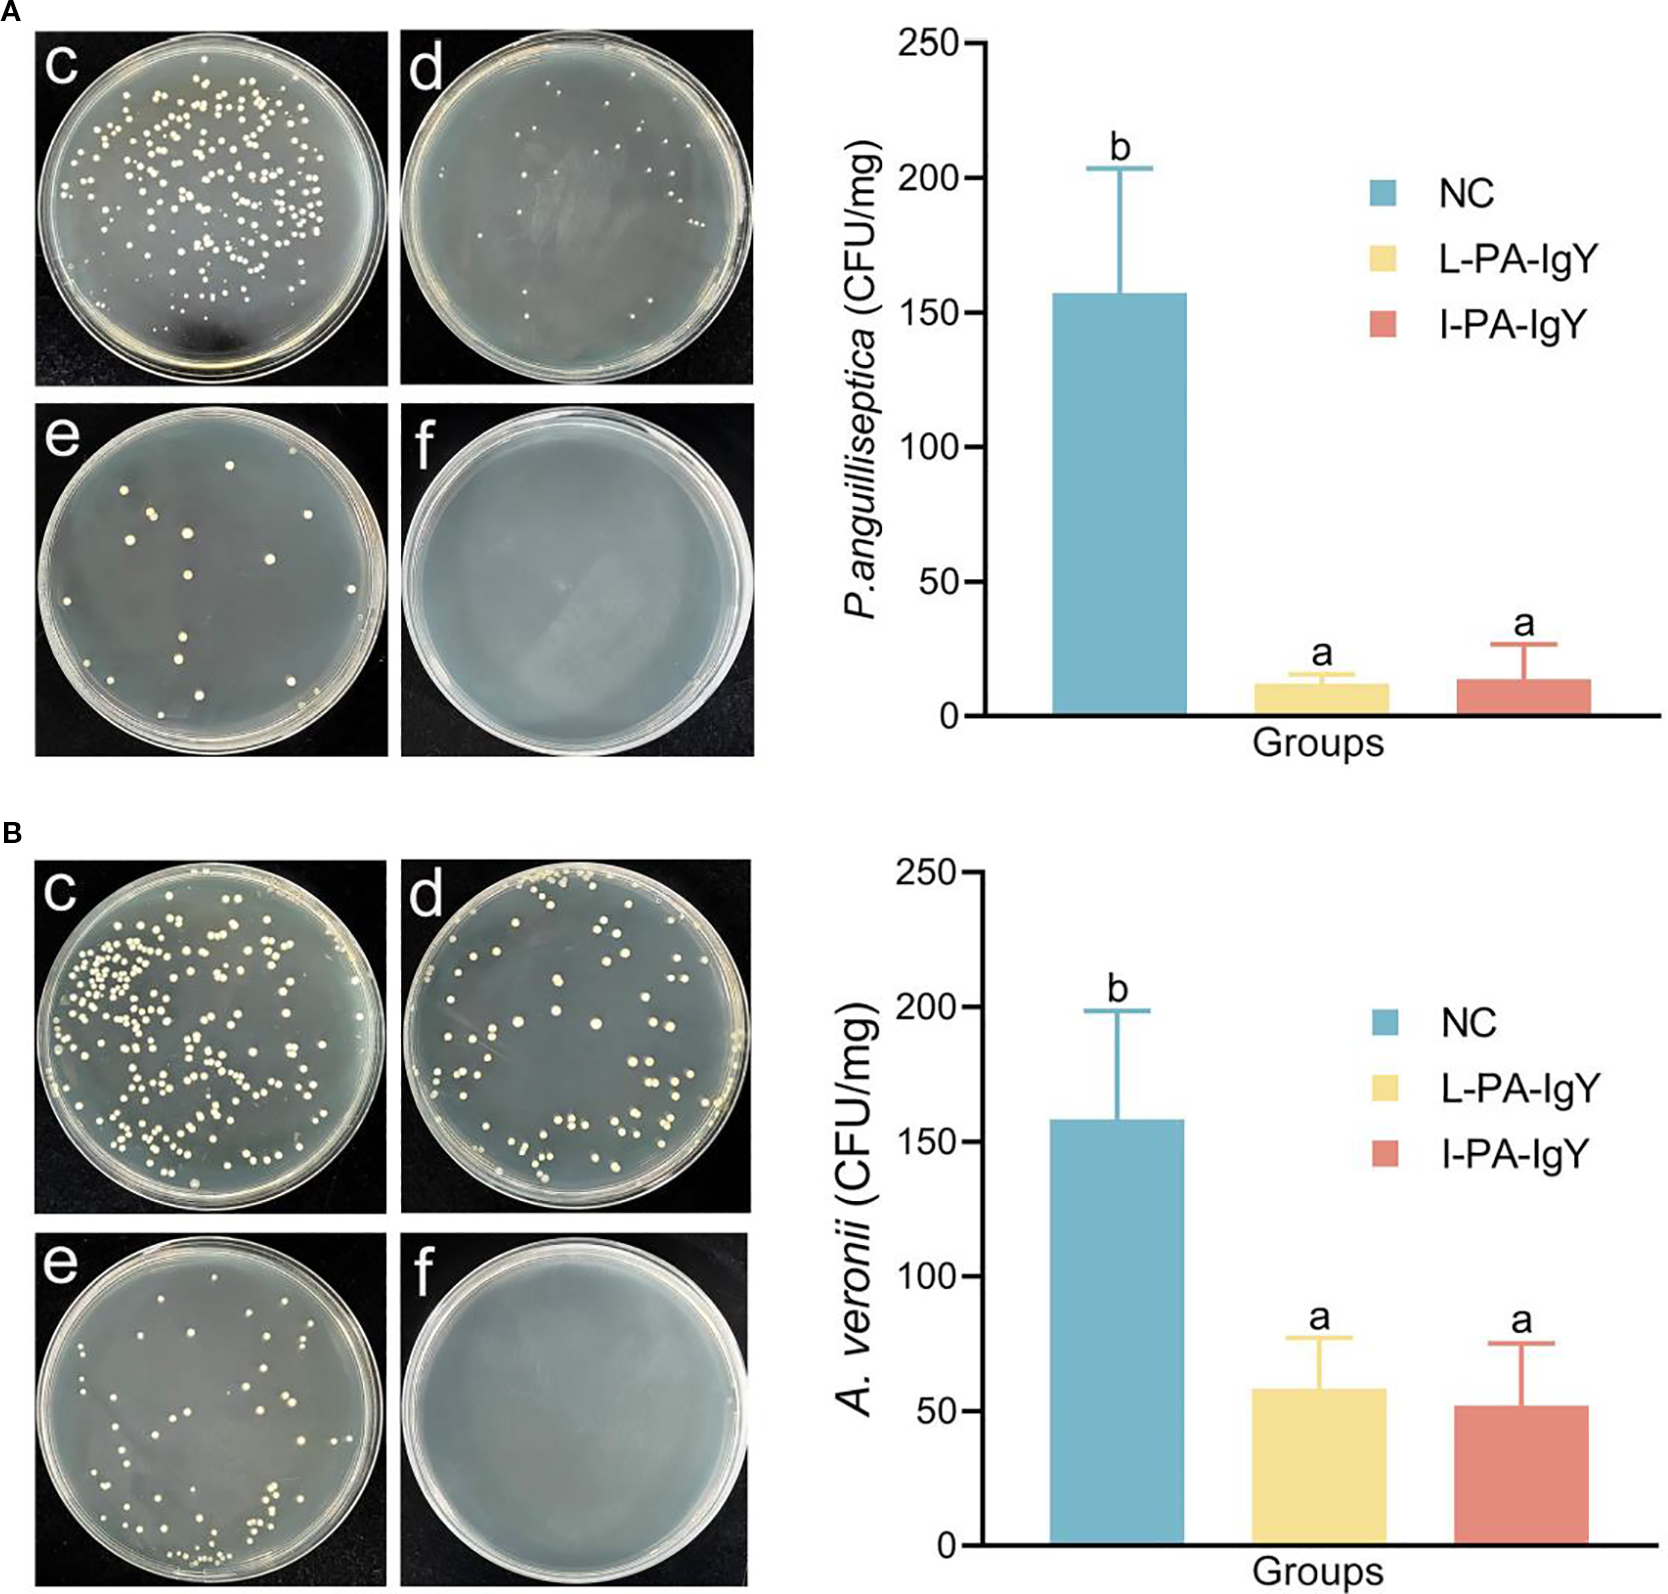
Petri dishes and bar graphs show bacterial growth and inhibition. (A) P. anguilliseptica: Petri dishes with varying bacterial colonies. A bar graph on the right shows bacterial count, with NC having the highest count, and L-PA-IgY and I-PA-IgY significantly lower. (B) A. veronii: Similar Petri dishes with bacterial colonies. The accompanying graph indicates NC with the highest count, with L-PA-IgY and I-PA-IgY reduced. “NC,” “L-PA-IgY,” and “I-PA-IgY” represent different sample treatments.

Abstract
Background:
Egg yolk immunoglobulin Y (IgY) can be produced on a large scale, with simple and economical preparation and no drug residue, making it promising for application in prophylactic multivalent passive immunization vaccines for aquaculture.
Methods:
IgY antibodies of live Pseudomonas anguilliseptica (L-PA-IgY) or inactivated P. anguilliseptica (I-PA-IgY) were prepared by immunizing laying hens. Carassius auratus individuals were passively immunized with the two types of IgY antibodies and then challenged with P. anguilliseptica and Aeromonas veronii to detect the immune protection rate. The kidneys were homogenized and coated on Luria–Bertani (LB) solid medium to assess their bacterial content. Additionally, a cell phagocytosis assay was conducted to detect leukocyte phagocytosis. C. auratus serum was obtained to evaluate the recognition of the two bacteria by enzyme-linked immunosorbent assay (ELISA), and the expression of antioxidant factors [superoxide dismutase (SOD), catalase (CAT), and glutathione peroxidase (GSH-Px)]. Furthermore, real-time fluorescence-based quantitative PCR (qRT-PCR) was performed to assess the expression of inflammatory factors (IL-6, IL-8, TNF-α, and IL-1β) in the kidney and spleen. Moreover, histopathological analysis was used to assess the integrity of visceral tissue structure, and immunofluorescence analysis was employed to assess the expression of apoptosis factor (p53) and DNA damage factor (γH2A.X) in the kidney.
Results:
The results indicated that the IgY antibodies of L-PA-IgY or I-PA-IgY exhibited passive immune protection against P. anguilliseptica and A. veronii. The sera of C. auratus passively immunized with L-PA-IgY or I-PA-IgY could interact with the two bacteria. Additionally, in C. auratus, the two IgY antibodies enhanced the phagocytic activity of leukocytes, reduced bacterial content in the kidneys, and diminished the expression of inflammatory and antioxidant factors. Furthermore, the structures of the kidney, spleen, and intestinal tissues were intact, and the expression of p53 and γH2A.X decreased in the kidney.
Conclusion:
L-PA-IgY and I-PA-IgY can resist multiple bacterial infections and have immunoprotective effects with no significant differences. Moreover, the inactivated P. anguilliseptica immunization in laying hens is in line with animal welfare standards, and I-PA-IgY can serve as an immunization strategy of a prophylactic multivalent passive vaccine to resist multiple bacterial infections in aquaculture.
1 Introduction
With the increasing concern for high-quality nutrition and food safety, the consumption of aquatic products has surged significantly (Zhao et al., 2024; Budhathoki et al., 2022). Bacterial diseases caused by fish pathogens have resulted in severe losses to the aquaculture industry. Most of these pathogens are opportunistic bacteria (Borges et al., 2021); they can remain latent in fish for extended periods without causing diseases but may rapidly lead to disease outbreaks or epidemics when the environment changes abruptly, when it becomes contaminated, or when the fish’s resistance declines (Ben Hamed et al., 2018). The main pathogenic bacteria in aquaculture include Pseudomonas anguilliseptica, Aeromonas veronii, Aeromonas hydrophila, Vibrio fluvialis, Edwardsiella tarda, and Vibrio parahaemolyticus (Sadat et al., 2021; Sasikumar et al., 2024). P. anguilliseptica is the pathogen responsible for red spot disease in eels and ayu fish. This bacterium is a Gram-negative, slender rod with a single polar flagellum, and its motility varies depending on the culture conditions. It primarily infects Japanese eels and ayu fish by invading the underlying layers of the fish’s epidermis and dermis. This process causes the capillaries distributed in these areas to become congested, leading to exudative hemorrhage or rupture, thereby forming punctate or patchy hemorrhages, which are referred to as red spot disease. The hemorrhagic spots of red spot disease are mainly distributed on the skin around the lower jaw, abdomen, or anus of the affected fish. Affected ayu fish often develop ulcers on their body surface (Mjølnerød et al., 2021; Sanahuja et al., 2019). A. veronii is a Gram-negative bacterium widely found in water and soil, which is capable of infecting humans and aquatic animals, causing symptoms such as skin ulcers or sores, organ hemorrhage, and severe ascites in aquatic animals (Guo et al., 2023). P. anguilliseptica and A. veronii can infect aquaculture fish such as eels, goldfish, tilapia, and sea bass and cause economic losses in the aquaculture industry. Additionally, P. anguilliseptica and A. veronii are conditional pathogens in humans and animals, which are the etiologic agents of zoonosis.
Due to the slow growth and metabolism rate of P. anguilliseptica, as well as the presence of structures such as extracellular capsules, the use of antibiotics and chemical drugs for prevention or treatment has shown limited efficacy. Instead, they can lead to various issues such as pathogen resistance, drug residues, food safety concerns, and environmental pollution (Cantillo Villa et al., 2023; Sakulworakan et al., 2021). Research has found that incorporating 3% garlic extract or 0.5% potassium diformate into the diet of cultured sea bream could improve their health status and increase their survival rate when faced with P. anguilliseptica infection (Fadel et al., 2018). This method can complement antibiotic treatment for P. anguilliseptica. However, the dosage and formulation of dietary supplements are difficult to standardize, making large-scale production unfeasible. Therefore, an integrated prevention and control technology system based on vaccine immunization technology is an important means for the prevention and control of this pathogen. A formalin-inactivated vaccine for P. anguilliseptica was applied to olive flounder. After being challenged with P. anguilliseptica, the relative percent survival (RPS) of vaccinated fish significantly increased, and the expression of TNFR-1, FasL, IRF7, TLR2, IL-1b, and CD40 genes was significantly upregulated (Jang et al., 2014). The upregulation of these genes and the increase in RPS values indicate that the formalin-inactivated P. anguilliseptica vaccine may play an important role in immunizing olive flounder against P. anguilliseptica.
Additionally, A. veronii is a major pathogen in aquaculture. The treatment of A. veronii includes the use of antibiotics such as sulfadiazine, sulfamethoxydiazine, enrofloxacin, and quinolones. Chinese herbal medicines such as Wu Mei, Wu Bei Zi, and Su Mu also have certain antibacterial effects against A. veronii, but their high cost makes them impractical for actual production (Sun et al., 2024). Vaccination is a fundamental method for preventing and controlling A. veronii. Crucian carp were immunized with inactivated A. veronii vaccine and then challenged with A. veronii. It was found that the inactivated vaccine increased the specific IgM levels against A. veronii in the fish (Guo et al., 2023). Previous studies have constructed an attenuated vaccine mutant strain of A. veronii and found that it could enhance the immune ability of largemouth bass (Micropterus salmoides) to resist A. veronii infection (Chi et al., 2023).
Although there has been some progress in vaccine research on the prevention and control of P. anguilliseptica and A. veronii, these studies are still in the laboratory research stage. More attention is now being paid to multivalent vaccine research because multivalent vaccines can protect against multiple bacterial infections, making them ideal vaccines for the aquaculture industry (Du et al., 2022; Miryala and Swain, 2025; Peng et al., 2021).
Egg yolk immunoglobulin Y (IgY) is a high-yield, high-quality polyclonal antibody (Pacheco et al., 2023). The large-scale industrial rearing of laying hens is cost-effective and economically convenient, and the process of preparing IgY is relatively simple. Using IgY as a substitute for antibiotics does not lead to drug residues, making it a safe and green additive (Pacheco et al., 2023; Wang et al., 2023). It can also be used as a passive polyvalent vaccine in aquaculture. In response to the economic losses in the aquaculture industry caused by Vibrio alginolyticus infection in the high-value shellfish abalone (Haliotis diversicolor supertexta), in this study, an alginate-encapsulated anti-Vibrio IgY egg powder feed was developed (Wu et al., 2011). The experiments confirmed that abalones fed with 5%–10% anti-Vibrio IgY achieved a survival rate of 65%–70% after pathogen challenge, significantly higher than the 0% survival rate in the control group. These results indicate that anti-Vibrio IgY can effectively trigger passive immunity, providing a practical prevention and control method for abalone farming. Studies have shown that specific IgY antibodies can be prepared by immunizing hens with formaldehyde-inactivated Vibrio cholerae O1. Oral administration of these antibodies to infected mice significantly increased the survival rate, which reached 60% at 6 h post-infection in the 5 mg/mL group (Shoushtari et al., 2023). The experiment confirmed that IgY could effectively neutralize the pathogen and reduce mortality. However, research on IgY vaccines against P. anguilliseptica and A. veronii is still relatively scarce.
The complete proteome and genome sequence of goldfish (Carassius auratus) is clear, and C. auratus is an edible and ornamental fish that is relatively easy to raise. In this study, C. auratus was used as the evaluation fish for the treatment of P. anguilliseptica and A. veronii (Liu et al., 2024a; Xiao et al., 2025a). IgY antibodies against live P. anguilliseptica (L-PA-IgY) or inactivated P. anguilliseptica (I-PA-IgY) were prepared by immunizing laying hens with live or inactivated P. anguilliseptica. This is an economical process and allows for the production of large quantities of IgY antibodies, which were then used for the passive immunization of C. auratus, followed by challenge with P. anguilliseptica or A. veronii. By comprehensively comparing the differences between L-PA-IgY and I-PA-IgY in terms of the immune protection rate, bacterial count in fish viscera, antioxidant response, inflammatory response, histopathology of visceral tissues, and cellular function (Figure 1), we provide technical support for research on prophylactic multivalent passive IgY vaccines.
Figure 1

Experimental process.
2 Materials and methods
2.1 Bacterial strains and animals
Bacterial strains, including P. anguilliseptica MatS1, A. veronii ATCC 35622, and Staphylococcus aureus ATCC 6538, were preserved in the Microbiology Laboratory of Fuyang Normal University, Anhui Province, China. Twenty-week-old laying hens were purchased from Chongqing Tengxin Biotechnology Co., Ltd. (Chongqing, China). C. auratus (20 ± 1.0 g) individuals were purchased from Fuyang Economic Fish Farming Co., Ltd. (Fuyang, China). All animal experiments were conducted in accordance with the “Guide for the Care and Use of Laboratory Animals” and approved by the Institutional Animal Care and Use Committee of Fuyang Normal University, China (No. 2024-04-006).
2.2 Preparation of IgY antibodies
P. anguilliseptica was cultured in 600 mL of Luria–Bertani (LB) liquid medium at 30°C overnight. Bacterial cells were collected via centrifugation, and a portion of the cells was dissolved in a 1% formaldehyde physiological saline solution and inactivated in an 80°C water bath for 90 min to prepare inactivated bacteria. Then, the bacteria were spread on LB solid medium and cultured overnight at 30°C. No bacteria grew on the plates, which proved that they were inactivated. Both live or inactivated P. anguilliseptica [2 × 107 colony-forming unit (CFU)] (200 μL each) and 200 μL of normal saline as a blank IgY antibody group (control) were intramuscularly injected into laying hens. Immunization was performed three times, with an interval of 14 days between each immunization. Eggs were collected 35 days after immunization and stored at 4°C. After 35 days, the eggs were taken, the yolks separated, and an equal volume of a phosphate-buffered saline (PBS) solution was added to the yolk solution. While stirring, 3.5% of powdered PEG6000 was added, mixed thoroughly, and centrifuged at 10,000 r/min for 20 min to collect the supernatant. Then, while stirring, 8.5% of powdered PEG6000 was continuously added to the supernatant, which was then centrifuged, and the precipitate was collected. The precipitate was dissolved in 10 mL of the PBS solution, and while stirring, 12% of powdered PEG6000 was added. After another centrifugation, the precipitate was dissolved in 2 mL of the PBS solution. The solution was dialyzed in PBS at 4°C for 36 h. The main component of the solution was IgY antibodies against live P. anguilliseptica (L-PA-IgY) or inactivated P. anguilliseptica (I-PA-IgY), and the two IgY antibodies were prepared (Xiao et al., 2025a). The purified production of IgY antibodies was detected using the method of sodium dodecyl sulfate–polyacrylamide gel electrophoresis (SDS–PAGE). The concentration of IgY antibody was adjusted to 2 μg/μL using a bicinchoninic acid (BCA) protein analysis kit (Shanghai Beyotime Biotech Co., Ltd., Shanghai, China).
2.3 IgY antibody titer detection
Enzyme-linked immunosorbent assay (ELISA) was used for IgY titer detection as described previously (Xiao et al., 2024). P. anguilliseptica was cultured in LB liquid medium at 30°C to an OD600 = 1.0. The bacteria were centrifuged and adjusted to OD600 = 1.0 with normal saline. The bacterial solution was then placed in a 96-well plate with 200 μL per well and coated overnight at 4°C. The wells were washed three times with the PBS solution. A total of 200 μL of 5% skimmed milk was added to the wells to seal at 37°C for 2 h. Then, L-PA-IgY, I-PA-IgY, and the IgY (without bacterial immunization) as a negative control (NE-C) were diluted in multiples with the PBS solution (1:200, 1:400, 1:800, 1:1,600, 1:3,200, and 1:6,400). Each dilution gradient was repeated six times. The wells were added with 200 μL of the IgY solution. After incubation at 37°C for 2 h, the wells were washed three times with the PBS solution. Furthermore, goat anti-IgY secondary antibody (1:500) (Sanying Biotechnology Co., Ltd., Wuhan, China) was added to the wells and incubated at 37°C for 1 h. After washing with PBS three times, the chromogenic solution was added to the wells and incubated at 37°C for 15 min. Absorbance at OD450 was immediately read using a microplate reader (Bio-Rad, Hercules, CA, USA).
2.4 Passive immunization with IgY antibody and bacterial challenge
C. auratus individuals were divided into two groups: challenge with P. anguilliseptica and A. veronii. Each group included a blank IgY group as a nature control (NC), an L-PA-IgY group, and an I-PA-IgY group, with 15 fish in each group. Each fish was intraperitoneally injected with 20 μL of IgY antibodies (40μg). According to the preliminary experiment, the median lethal dose (LD50) of P. anguilliseptica was determined to be 8 × 108 CFU, and that of A. veronii was 1 × 109 CFU. Two hours after IgY passive immunization, the fish were intraperitoneally challenged with P. anguilliseptica (8 × 108 CFU) and A. veronii (1 × 109 CFU). The mortality of the fish was observed for 14 consecutive days. The RPS was calculated using the following formula: RPS (%) = (1 − [mortality rate in the experimental group %/mortality rate in the control group %]) × 100 (Xiao et al., 2024).
2.5 Interaction between C. auratus serum and bacteria
P. anguilliseptica and A. veronii were cultured in 300 mL of LB liquid medium at 30°C to an OD600 = 1.0. The bacteria were centrifuged and adjusted to OD600 = 1.0 with normal saline. The bacterial solution was then placed in a 96-well plate, with 200 μL per well, and coated overnight at 4°C. The wells were washed three times with a tris-buffered saline with tween-20 (TBST) solution for 10 min each time. A total of 200 μL of 5% skimmed milk was added to the wells; then, the plate was sealed and incubated at 37°C for 2 h. Meanwhile, C. auratus was passively immunized with L-PA-IgY, I-PA-IgY, and blank IgY as a nature control (NC). Additionally, the fish without IgY immunization or bacterial infection were used as a negative control (NE-C). After 2 h of passive immunization with IgY, C. auratus was challenged with P. anguilliseptica or A. veronii. After 2 days, C. auratus serum was obtained from the tail vein. Then, gradient dilutions (1:200, 1:400, 1:800, 1:1,600, 1:3,200, and 1:6,400) of C. auratus serum were sequentially added to the wells and incubated at 37°C for 2h. Three wells were used per dilution, and the experiment was repeated three times. After washing, rat anti-fish IgM secondary antibody (1:400) (Sanying Biotechnology Co., Ltd., Wuhan, China) was added to the wells and incubated at 37°C for 1h. After washing with TBST, goat anti-rat tertiary antibody (1:2,500) (Sanying Biotechnology Co., Ltd., Wuhan, China) was added to the wells and incubated at 37°C for 1h. After washing with TBST three times, the chromogenic solution was added and incubated at 37°C for 15 min to terminate the reaction. Absorbance at OD450 was immediately read using a microplate reader (Bio-Rad, Hercules, CA, USA) (Xiao et al., 2024).
2.6 Kidney bacterial content
The kidney count was used to evaluate the effect of IgY antibody on bacterial clearance, as previously described (Xiao et al., 2025b). Briefly, C. auratus individuals were divided into two groups: challenge with P. anguilliseptica and A. veronii. Each group included a blank IgY group as a nature control (NC), an L-PA-IgY group, and an I-PA-IgY group, with 10 fish in each group. Additionally, to detect bacterial contamination, the fish without IgY immunization or bacterial challenge were taken as a negative control group (NE-C). Each fish was intraperitoneally injected with 20 μL of IgY antibodies (40μg). After 2 h, the fish were intraperitoneally challenged with P. anguilliseptica (8 × 108 CFU) and A. veronii (1 × 109 CFU). Six kidney tissues for each group were taken from C. auratus under anesthesia on the second day after being challenged with bacteria. For subsequent testing, 50 mg of kidney per fish was weighed. After thoroughly grinding, the kidney tissue was added to 200 μL of the physiological saline solution. Then, the kidney homogenates were diluted in serial 10-fold dilutions with the physiological saline solution, and 200 μL of diluent was spread onto selective culture media for cultivation overnight at 28°C. The selective culture medium that suppressed the growth of background flora for P. anguilliseptica was Pseudomonas CFC Selective Agar HB8689, and the selective culture medium for A. veronii was Aeromonas Medium Base (Ryan) Selective Agar HB7023 (Haibo Biotechnology Co., Ltd., Qingdao, China). The negative control group (NE-C) was used fully nutritious culture medium (LB) to detect the contamination status of bacteria in kidney tissues. Photographs were taken for a medium plate, and the bacterial colony count was determined. The dilution ratio of the kidney homogenates was reported as CFU values exclusively from plates with 30–300 countable colonies. Furthermore, five colonies were randomly selected from each selective culture medium for expansion culture, and 16S rDNA sequencing was performed by Sangon Biotech Co., Ltd. (Shanghai, China) to identify bacterial species to exclude the growth of background bacteria.
2.7 Leukocyte phagocytosis analysis
After passive immunization with IgY antibodies and challenge for 2 days, six blood samples were taken from C. auratus under anesthesia. S. aureus was transferred to 100 mL of LB liquid medium and incubated overnight at 37°C with shaking. The bacterial cells were then collected and dissolved in a 1% formaldehyde saline solution, followed by inactivation in a water bath at 80°C for 90 min. After the inactivation, the bacteria were adjusted to an OD600 = 0.6 with normal saline. A mixture of 200μL of anticoagulated blood and S. aureus suspension (1 × 106 CFU) was prepared, incubated in a 25°C water bath for 60 min, and gently inverted every 10 min to ensure thorough mixing. Blood smears were then prepared. After methanol fixation, staining was performed using a rapid Giemsa staining kit (Sangon Biotech Co., Ltd., Shanghai, China), and observation and counting were conducted under a microscope to calculate the phagocytic percentage and phagocytic index. The calculation methods were as follows. Phagocytic percentage (PP): number of cells involved in phagocytosis among 100 phagocytic cells/100 × 100%. Phagocytic index (PI): number of bacteria within phagocytic cells/number of counted cells involved in phagocytosis × 100% (Xiao et al., 2024).
2.8 Antioxidant factors and ROS analysis
Antioxidant factors and reactive oxygen species (ROS) were assessed in C. auratus serum as described previously (Xiao et al., 2025b). Briefly, on the second day of passive immunization with IgY antibodies and bacterial challenge, six sera in each group were obtained from the tail vein of C. auratus under anesthesia. The group passively immunized with blank IgY was used as a nature control (NC), and the group without IgY or bacteria was used as a negative control (NE-C). The antioxidant factor levels of catalase (CAT), glutathione peroxidase (GSH-Px), and superoxide dismutase (SOD) were assessed in accordance with the instructions provided in the detection kit (Nanjing Jiancheng Bioengineering Institute Co., Ltd., Nanjing, China). Additionally, the ROS of C. auratus serum was detected according to the kit manufacturer’s instructions (Nanjing Jiancheng Bioengineering Institute Co., Ltd., Nanjing, China).
2.9 Analysis of mRNA expression of inflammatory factors
Real-time fluorescence-based quantitative PCR (qRT-PCR) was used to evaluate the expression of inflammatory factor mRNA, as previously described (Xiao et al., 2024). Briefly, C. auratus individuals were passively immunized with IgY antibodies and challenged with P. anguilliseptica or A. veronii. The kidneys and spleens of six C. auratus individuals for each group were collected under anesthesia on the second day after challenge. The group passively immunized with blank IgY was used as a nature control (NC), and the group without IgY or bacteria was used as a negative control (NE-C). The tissues were thoroughly ground with liquid nitrogen, and RNA was extracted using an RNA extraction kit (Sangon Biotech Co., Ltd., Shanghai, China). The RNA was then converted to cDNA using a reverse transcription kit (Servicebio Biotechnology Co., Ltd., Wuhan, China). qRT-PCR was performed using the SYBR® Green Premix kit (Servicebio Biotechnology Co., Ltd., Wuhan, China) and synthesized primers (Supplementary Table S1). The ΔCt (cycle threshold change) was determined by comparing the Ct values of the factor genes with those of the reference gene (gapdh), and then the ΔΔCt was determined by comparing the ΔCt values of the experimental group with those of the control group. Subsequently, mRNA expression was analyzed using the 2−(ΔΔCt) formula.
2.10 Histopathological analysis
Two days after passive immunization with IgY and bacterial challenge, C. auratus kidney, spleen, and intestinal tissues were obtained and immersed in Davidson’s fixative for 18 h and then transferred to a 10% formaldehyde solution for fixation for more than 24 h. The tissues were then dehydrated in a gradually increasing concentration gradient of ethanol (80%, 90%, 95%, and 100%), followed by clearing in xylene. Afterward, the samples were embedded in paraffin at 65°C to form paraffin blocks. The blocks were then sectioned into 4-μm-thick slices using a microtome, and the slices were placed on adhesive slides and dried overnight at 37°C. The slides were sequentially immersed in xylene and a gradient of decreasing ethanol concentrations (100%, 95%, 80%, and 70%) to dewax and rehydrate them. After rinsing with tap water, the sections were stained with hematoxylin and eosin, dehydrated with ethanol, and cleared with xylene. Finally, the slides were mounted with a neutral resin. The structural integrity of the glomeruli and renal tubules in the kidney tissue, along with the cellular compactness of the spleen tissue and the structural changes in the mucosal layer cells of the intestine of the six C. auratus individuals for each group, was observed under a microscope (Leica, Wetzlar, Germany) (Xiao et al., 2025a).
2.11 Immunofluorescence analysis of tissue
The six prepared renal tissue sections for each group were dewaxed in xylene, hydrated in a decreasing ethanol gradient (100%, 95%, 80%, and 50%), and washed twice with phosphate buffered saline with tween-20 (PBST). After permeabilizing the cells with 1% Triton X-100, the slides were placed in a carbonate buffer solution (CBS) solution and boiled for 2 min for antigen retrieval. After natural cooling, the slides were immersed in 3% H2O2, washed twice with PBST, and circled with an immunohistochemical pen around the tissue. Then, 10 μL of a blocking solution (5% bovine serum albumin) was added within the circle and incubated at room temperature for 1.5 h, followed by three washes with PBST. p53 or γH2A.X antibodies (1:200) were added to the tissue section and incubated at 37°C for 2 h. After PBST washing, a donkey anti-rabbit (1:250) secondary antibody solution was added to the tissue section, and the section was incubated at 37°C for 1 h. After PBST washing, the nuclei were stained with 4′,6-diamidino-2-phenylindole (DAPI) at room temperature for 10 min and washed three times with PBST; the slides were mounted, and the expression of p53 and γH2A.X was observed under a fluorescence microscope (Leica, Wetzlar, Germany) (Xiao et al., 2024).
2.12 Statistical analysis
All the experimental data were expressed as mean ± SD, and all experiments were repeated at least three times. The significant difference from the respective control in all experiments was assessed by one-way analysis of variance (ANOVA) using the software of Statistical Package for the Social Sciences 19.0 (SPSS 19.0). Values of p < 0.05 were considered statistically significant (Dudley et al., 2004).
3 Results
3.1 Immune protection rate of IgY antibody
According to PEG6000 antibody purification technology, high-purity L-PA-IgY and I-PA-IgY were obtained (Supplementary Figure S1). The titer of L-PA-IgY and I-PA-IgY was 1:1,600 via the ELISA method (Supplementary Figure S2).
C. auratus individuals were passively immunized with L-PA-IgY or I-PA-IgY and then challenged with P. anguilliseptica and A. veronii. The results showed that the mortality of the fish stabilized after 4 days (Figure 2). The RPS values of live or inactivated bacterial IgY antibodies against P. anguilliseptica were 66.67% (p < 0.05) and 73.33% (p < 0.05), respectively, and their RPS values against A. veronii were 75.00% (p < 0.05) and 58.34% (p < 0.05), respectively. Using SPSS 19.0 for the chi-square test, it was found that there was no significant difference in RPS values (p > 0.05) between L-PA-IgY and I-PA-IgY. It is evident that both L-PA-IgY and I-PA-IgY possess passive immunoprotective effects.
Figure 2

Survival rates of Carassius auratus challenged with pathogenic bacteria. Challenged with Pseudomonas anguilliseptica(A) and Aeromonas veronii(B). NC represents C. auratus immunized with blank IgY antibody as the nature control. Each group consists of 15 fish. Many fish in the NC group died, and the mortality of fish in both the experimental group and the NC group stabilized on the fourth day.
3.2 Detection of the number of bacteria in C. auratus kidneys
To determine the bacterial count within C. auratus, kidney tissues from the fish were coated on LB medium on day 2 after passive immunization with IgY and bacterial challenge. Compared to those in the control group, the bacterial counts in both L-PA-IgY and I-PA-IgY groups were reduced (p < 0.05) (Figure 3). This indicates that L-PA-IgY and I-PA-IgY can reduce the number of bacteria in the kidneys, and the difference in effectiveness between the two IgY antibodies is not significant.
Figure 3
Kidney bacterial count statistics of Carassius auratus. (A) Challenged with Pseudomonas anguilliseptica. (B) Challenged with Aeromonas veronii. (c) Blank IgY group as a nature control (NC). (d) L-PA-IgY. (e) I-PA-IgY. (f) Negative control (the kidney of fish without IgY immunization or bacterial attack). Data are presented as the mean ± SD (n = 6). One-way ANOVA followed by Tukey’s multiple comparison test was used to compare the differences. Labels a–b indicate statistically different groups (p < 0.05).
3.3 Detection of phagocytic activity in blood of C. auratus
To evaluate the phagocytosis of leukocytes, blood from C. auratus individuals passively immunized with two types of IgY antibodies and then challenged with bacteria was subjected to a leukocyte phagocytosis assay. The blood smears are shown in Supplementary Figure S3. The results showed that the phagocytic percentage (PP%) and phagocytic index (PI%) of leukocytes in the IgY groups increased (p < 0.05) (Table 1). This indicates that both L-PA-IgY and I-PA-IgY can activate leukocyte phagocytosis, with no significant difference between the two types of antibodies.
Table 1
| Bacteria | Group (IgY) | Phagocytic percentage (PP%) | Phagocytic index (PI%) |
|---|---|---|---|
| Challenge with Pseudomonas anguilliseptica |
Control | 30.82 ± 4.24b | 124.84 ± 6.32b |
| L-PA-IgY | 47.50 ± 3.80a | 146.04 ± 8.53a | |
| I-PA-IgY | 54.20 ± 9.66a | 145.01 ± 3.03a | |
| Challenge with Aeromonas veronii |
Control | 49.00 ± 2.53b | 100.53 ± 8.68b |
| L-PA-IgY | 65.33 ± 7.15a | 165.00 ± 35.16a | |
| I-PA-IgY | 53.00 ± 2.65b | 134.56 ± 10.12ab |
The phagocytosis experiment of leukocytes conducted on pathogenic bacteria in Carassius auratus blood.
Data are presented as the mean ± SD (n = 8). One-way ANOVA followed by Tukey’s multiple comparison test was used to compare the differences. Labels a and b indicate statistically different groups (p < 0.05).
3.4 Detection of antioxidant factors and ROS in C. auratus serum
After passive immunization with two IgY antibodies and pathogen challenge, C. auratus serum was collected for antioxidant factor detection. In the negative control group (NE-C), antioxidant-related factors (SOD, CAT, and GSH-Px) were the lowest compared to those in other groups. Compared with those in the control group (NC), the levels of most antioxidant-related factors (SOD, CAT, and GSH-Px) were decreased (p < 0.05) in the L-PA-IgY and I-PA-IgY groups (Figure 4). Additionally, after passive immunization with the two IgY antibodies and challenge with P. anguilliseptica, the levels of ROS in C. auratus serum were also decreased (p < 0.05) in the L-PA-IgY and I-PA-IgY groups (Supplementary Table S2). These results indicate that L-PA-IgY or I-PA-IgY immunization reduced oxidative pressure due to pathogen suppression in fish, the reduced enzyme activity likely results from lower ROS generation, and there is no difference between the two IgY antibodies.
Figure 4

CAT, SOD, and GSH-Px contents in serum. Challenged with Pseudomonas anguilliseptica(A) and Aeromonas veronii(B). NC represents Carassius auratus immunized with blank IgY antibody as the nature control. NE-C represents the negative control (fish without IgY immunization or bacterial attack). Data are presented as the mean ± SD (n = 6). One-way ANOVA followed by Tukey’s multiple comparison test was used to compare the differences. Labels a–c indicate statistically different groups (p < 0.05). CAT, catalase; SOD, superoxide dismutase; GSH-Px, glutathione peroxidase.
3.5 Detection of mRNA expression of inflammatory factors in C. auratus
After passive immunization of C. auratus individuals with L-PA-IgY or I-PA-IgY and challenge with P. anguilliseptica and A. veronii, their kidneys and spleens were collected to evaluate the mRNA expression of inflammation-related factors (IL-6, IL-8, TNF-α, and IL-1β). In the negative control group (NE-C), the mRNA expression of inflammatory factors (IL-6, IL-8, TNF-α, and IL-1β) was the lowest compared to that in other groups. Compared with that in the control (NC) group, the mRNA expression of IL-6, IL-8, TNF-α, and IL-1β in the kidneys and spleens was reduced (p < 0.05) in the L-PA-IgY and I-PA-IgY groups (Figure 5). The results indicate that L-PA-IgY and I-PA-IgY can reduce the inflammatory response induced by P. anguilliseptica and A. veronii in C. auratus, and the effects of the two IgY antibodies are not different.
Figure 5

mRNA expression of inflammatory factors in tissues. Challenged with Pseudomonas anguilliseptica(A) and Aeromonas veronii(B). NE-C represents the negative control. NC represents the blank IgY group. Data are presented as the mean ± SD (n = 6). One-way ANOVA followed by Tukey’s multiple comparison test was used to compare the differences. Labels a–c indicate statistically different groups (p < 0.05).
3.6 In vitro interaction of C. auratus serum with bacteria
To detect the in vitro interaction between C. auratus serum and bacteria, the serum of C. auratus passively immunized with IgY and post-challenge bacteria underwent an ELISA. The results showed that the serum could bind to P. anguilliseptica and A. veronii in the L-PA-IgY or I-PA-IgY group. Additionally, the absorbance decreased with the increase in dilution of C. auratus serum, and the recognition was assessed at a dilution of 1:6,400 (Figure 6).
Figure 6

The interaction between bacteria and the serum of Carassius auratus immunized with IgY and challenged with Pseudomonas anguilliseptica or Aeromonas veronii. Challenged with P. anguilliseptica(A) and A. veronii(B). NE-C represents the negative control. NC represents the blank IgY group. Data are presented as the mean ± SD (n = 6). One-way ANOVA followed by Tukey’s multiple comparison test was used to compare the differences.
3.7 Histopathological observation of C. auratus viscus
An organ pathological section experiment was conducted to evaluate the visceral damage in C. auratus after passive immunization with IgY antibodies and challenge with pathogenic bacteria. The results showed that the renal tissue structure in the control group (NC) was incomplete, with a higher degree of atrophy and degeneration in the glomeruli and renal tubules; the cellular density of the splenic tissue was reduced, and the tissue structure was incomplete; the intestinal tissue structure was loose, with atrophy and apoptosis observed in some areas of the mucosal layer. The renal, splenic, and intestinal structures in the L-PA-IgY, I-PA-IgY, and NE-C groups were more intact compared to those in the NC group, with no significant differences between the two types of IgY antibodies (Figure 7).
Figure 7

Pathological sections of kidney, spleen, and intestinal tissues of Carassius auratus (n = 6). Challenged with Pseudomonas anguilliseptica(A) and Aeromonas veronii(B). NE-C represents the negative control. NC represents the blank IgY group.
3.8 Immunofluorescence analysis of C. auratus kidneys
Immunofluorescence analysis was performed to evaluate the apoptosis and DNA damage in C. auratus kidney cells. Red represents p53 and γH2A.X, and blue represents DAPI-stained nuclei. In the negative control group (NE-C), the expression of p53 and γH2A.X was the lowest compared to that in other groups. Compared to that in the control group (NC), the expression of p53 and γH2A.X was reduced in the L-PA-IgY or I-PA-IgY group (p < 0.05) (Figure 8). The results indicate that passive immunization with L-PA-IgY or I-PA-IgY can reduce apoptosis and DNA damage in the kidney cells of C. auratus.
Figure 8

Immunofluorescence analysis of p53 and γH2A.X proteins in the kidney of Carassius auratus. Challenged with Pseudomonas anguilliseptica(A) and Aeromonas veronii(B). Red represents p53 and γH2A.X, and blue represents DAPI-stained nuclei. NE-C represents the negative control. NC represents the blank IgY group. Data are presented as the mean ± SD (n = 6). One-way ANOVA followed by Tukey’s multiple comparison test was used to compare the differences.
4 Discussion
The immune survival rate is a core indicator for evaluating vaccine efficacy, directly reflecting the vaccine’s ability to elicit protective immunity in the body (Feng et al., 2018). A high survival rate indicates that the vaccine can significantly reduce the risk of fatal infection, providing reliable protection for disease prevention and control (Peralta et al., 1994; Peng et al., 2018). The survival rate of Litopenaeus vannamei with acute hepatopancreatic necrosis disease (AHPND) caused by V. parahaemolyticus reached 87% when fed with anti-PirA IgY (p < 0.01) (Nakamura et al., 2019). The experiment showed that a dose of 10 mg/kg of anti-Shigella IgY could reach an 80% survival rate in mice (p < 0.01) (Felegary et al., 2024). To determine the optimal time for bacterial challenge after IgY immunization in goldfish, in preliminary experiments, goldfish individuals were immunized with IgY (40 μg per fish) and subsequently challenged with P. anguilliseptica at different time intervals (0.5, 1, 1.5, 2, 2.5, and 3 h). It was found that the immunoprotective effect of IgY was more pronounced when the bacterial challenge was administered at 2 h post-immunization. Furthermore, it was found that the immune activity of IgY can persist for more than 10 days in fish. In this study, after passive immunization with L-PA-IgY or I-PA-IgY in C. auratus and challenge with pathogenic bacteria, it was found that the two IgY antibodies could provide passive immunoprotective efficiency against different bacterial species. Therefore, L-PA-IgY and I-PA-IgY have the potential to be candidates for multivalent vaccines in fish.
Non-specific immune indicators reflect the overall function of an animal’s immune system. These indicators can reveal the regulatory effects of vaccines on the overall immune status of the organism (Netea et al., 2019). The evaluation criteria include white blood cell count, detection of immune-active factors, bacterial techniques in visceral tissues, and in vitro interactions between antibodies and bacteria (Zhang et al., 2024a). The experiment prepared specific IgY antibodies based on the outer membrane proteins (OMPs) of V. parahaemolyticus. In vitro experiments confirmed that this IgY antibody selectively inhibits the growth of V. parahaemolyticus. In vivo feeding with IgY significantly reduced the bacterial load in the muscle of infected shrimp compared to the non-specific IgY group (Hu et al., 2019). In this study, a specific antibody against the outer membrane proteins of Pseudomonas fluorescens was prepared. Through in vitro experiments, they found that the bacterial count in the kidneys of C. auratus was significantly lower in the IgY antibody group compared to the control group (blank IgY group) (p < 0.05) (Liu et al., 2023). In addition, IgY antibodies against A. hydrophila were prepared. After passively immunizing blunt snout bream (Megalobrama amblycephala) and challenging them with the pathogen, they found that IgY antibodies not only inhibited the proliferation of the pathogen but also significantly enhanced the host’s immune clearance capability by activating the phagocytic activity of macrophages (Qin et al., 2018). Studies have found that IgY targeting Pseudomonas aeruginosa can opsonize the pathogen and enhance the respiratory burst mediated by polymorphonuclear neutrophils and subsequent in vitro bacterial killing, thereby enhancing innate immunity against P. aeruginosa in a non-chronic infection cystic fibrosis environment (Thomsen et al., 2016). A specific IgY antibody against the outer membrane proteins of A. hydrophila was prepared, and ELISA experimental results showed that the serum of C. auratus passively immunized with IgY antibodies and challenged bacteria still exhibited specific binding with the bacteria at a dilution of 1:3,200 (Liu et al., 2024a). In this experiment, IgY passive immunization of C. auratus was performed, followed by bacterial infection challenge, after which kidney bacterial count and cellular phagocytosis assays were conducted. The results showed a significant decrease in the kidney bacterial count of C. auratus (p < 0.05) and a significant increase in both the phagocytic index and phagocytic percentage of cells in the blood of C. auratus (p < 0.05). ELISA results indicated that there was still an interaction between the serum of C. auratus and the bacterial cells at a dilution of 1:6,400. The above results demonstrate that L-PA-IgY and I-PA-IgY can significantly enhance the innate immune response of C. auratus, thereby improving its defense capability against exogenous pathogen invasion.
Antioxidant enzymes are key enzymes in organisms that scavenge free radicals and maintain the redox balance, and their activity changes are closely related to the health, diseases, and environmental adaptation of the organism (Zhong et al., 2022). Antioxidant factors include SOD, CAT, GSH-Px, and malondialdehyde (MDA) (Jomova et al., 2024). Inflammatory factors are key mediators in the immune system that regulate inflammatory responses, and they can be classified into pro- and anti-inflammatory factors based on their functions. Pro-inflammatory factors include IL-6, IL-8, IL-1β, and TNF-α, while anti-inflammatory factors include IL-10, TGF-β, and IL-1Ra (Kim et al., 2022; Chen et al., 2024). The balance between the two is a critical point in disease prevention and treatment. The results showed that the expression levels of SOD, CAT, and GSH-Px were significantly decreased (p < 0.05), and the expression levels of pro-inflammatory cytokines IL-6, IL-8, IL-1β, and TNF-α were also significantly decreased (p < 0.05) in the kidney and spleen of C. auratus immunized with live and inactivated V. fluvialis IgY antibodies (Liu et al., 2024b). The specific IgY antibody was prepared and passively fed to tilapia (Oreochromis niloticus) for 10 consecutive days, followed by a challenge with Streptococcus agalactiae. The results showed that the specific IgY antibody could reduce the apoptosis of intestinal epithelial cells and decrease caspase activity in tilapia; meanwhile, the MDA content was reduced. Additionally, the specific IgY antibody also downregulated the expression levels of IL-8 and TNF-α genes and upregulated the expression levels of IL-10 and TGF-β (Zhang et al., 2024b). Adding different concentrations of Bacillus licheniformis (BL) to broiler feed resulted in a significant increase in serum IL-10 levels in the BL-supplemented group, while IL-1β, TNF-α, and IL-2 levels decreased (Qin et al., 2024). Additionally, BL supplementation significantly enhanced the total antioxidant capacity in the serum. In this study, after passive immunization with IgY antibodies and bacterial challenge, the levels of most antioxidant-related factors (SOD, CAT, and GSH-Px)and ROS in the serum of C. auratus were significantly reduced (p < 0.05). This indicates that reduced SOD, CAT, and GSH-Px levels are more straightforwardly explained by decreased demand for these enzymes due to lower ROS (possibly from reduced pathogen load), maintaining stable oxidative reactions. In addition, the expression levels of pro-inflammatory factors in C. auratus kidney and spleen tissues were detected, and the mRNA expression of IL-1β, TNF-α, IL-6, and IL-8 was significantly decreased (p < 0.05), indicating that the pathogen’s ability to attack C. auratus was weakened, further confirming the anti-inflammatory effect of IgY antibodies. Therefore, L-PA-IgY and I-PA-IgY have antioxidant and anti-inflammatory effects in fish.
Histopathological section experiments revealed changes in tissue morphology and structure to identify the location and extent of the damage (Jiang et al., 2023). Immunofluorescence experiments utilized specific antibodies to label target proteins, precisely locating the expression distribution and abundance of signaling molecules in tissues, revealing DNA damage and cell apoptosis (Tan et al., 2020). Highly purified IgY antibodies of nervous necrosis virus (NNV) or non-specific IgY were added to the feed of mandarin fish, followed by artificial infection with NNV. Histopathological analysis revealed vacuolar lesions in the brain tissue of mandarin fish in the non-specific IgY group, while only slight vacuolation was observed in the brain tissue of the NNV IgY group (Liang et al., 2024). After intraperitoneal injection of the outer membrane vesicles (OMVs) of Porphyromonas gingivalis into adult zebrafish, coagulation, edema, and sponge-like proliferation were observed in the brain tissue of zebrafish (Adewoyin et al., 2024). Furthermore, proteins p53 and γH2A.X are often used as indicators of cell apoptosis and DNA damage, respectively. The p53 protein signaling pathway can regulate multiple downstream target genes to participate in apoptosis, autophagy, DNA repair, and cell cycle arrest. The p53 activates pro-apoptotic genes such as Bcl-2-associated X protein (Bax) and cysteine-dependent aspartate-specific protease-3 (Caspase-3), inducing the cell apoptosis pathway (Moshrefi et al., 2017). Additionally, p53 binds to DNA replication protein A (RPA), halting the DNA replication process, which results in cell cycle arrest at the G1 phase, thereby inducing apoptosis (Dutta et al., 1993). γH2A.X is a histone variant, and the phosphorylation of histone H2A.X into γH2A.X is a crucial early event in the DNA damage response, marking DNA damage sites and initiating repair processes (Xu et al., 2024). After injecting the aging inducer into mice, the levels of γH2A.X, p53, and p21 significantly increased in their bodies (Kumar et al., 2024). Experiments had shown that fatty acid amide hydrolase has a protective effect on mice with kidney injury, and the results showed that the expression levels of p53 and p21 were reduced in the kidney tissues of the mice (Chen et al., 2025). Protein, DNA, and IgY vaccines for the outer membrane protein VF14355 of V. fluvialis were prepared and used to passively immunize C. auratus, which were subsequently challenged with V. fluvialis and A. hydrophila. The results showed that apoptosis factor p53 and DNA damage factor γH2A.X were significantly reduced (p < 0.05) in the kidney tissues (Xiao et al., 2025b). Histopathological experiments revealed that the organ structures remained intact. In this study, passive immunization with L-PA-IgY and I-PA-IgY can maintain the integrity of visceral tissues and decrease the expression of p53 and γH2A.X to resist bacterial challenge in fish. These findings indicate that L-PA-IgY and I-PA-IgY not only protect the morphological integrity of the organs but also effectively reduce the apoptosis and DNA damage caused by pathogenic bacteria.
Additionally, in this study, the live or inactivated P. anguilliseptica IgY antibody had passive cross-protection abilities against A. veronii infection in fish. Nevertheless, the underlying mechanisms remain underexplored. Liu et al. [24] found that the IgY of outer membrane proteins (PF1380 and ExbB) of P. fluorescens has a passive cross-protection ability against A. hydrophila in goldfish, and they showed that the two proteins may exist as cross-antigens or conserved epitopes corresponding to the proteins of A. hydrophila. Additionally, some research found that live or inactivated V. fluvialis had passive cross-protection abilities against A. hydrophila infection in fish. There may be structurally similar epitopes between V. fluvialis and A. hydrophila to generate passive cross-protection abilities against A. hydrophila in fish [23,28]. Thus, it is possible that cross-antigens or similar epitopes exist between P. anguilliseptica and A. veronii in this research.
5 Conclusion
PA-IgY and I-PA-IgY antibodies were prepared. Prophylactic passive immune protection assessment was achieved by immunizing C. auratus with the two IgY antibodies and subsequently challenging the fish with pathogenic bacteria. The two IgY antibodies exhibited passive immune protection against pathogenic bacterial infection. Additionally, there is a mutual recognition interaction between C. auratus serum and bacteria, the phagocytic activity of leukocytes was enhanced, and the bacterial load in the kidneys was reduced. Furthermore, the expression of inflammatory and antioxidant factors decreased, and the tissue structures of the kidney, spleen, and intestine remained intact. The apoptosis and DNA damage in renal cells were also reduced. These results indicate that L-PA-IgY and I-PA-IgY demonstrate passive immunoprotective effects against multiple bacterial infections, with no significant differences between the two. Moreover, inactivated bacteria immunity in laying hens is in line with animal welfare standards, and I-PA-IgY is suitable for use as a multivalent prophylactic passive immunization vaccine against multiple bacterial infections in fish.
Statements
Data availability statement
The original contributions presented in the study are included in the article/Supplementary Material. Further inquiries can be directed to the corresponding author.
Ethics statement
The animal study was approved by All animal experiments were conducted in accordance with the “Guide for the Care and Use of Laboratory Animals” and approved by the Institutional Animal Care and Use Committee of Fuyang Normal University, China (No. 2024-04-006). The study was conducted in accordance with the local legislation and institutional requirements.
Author contributions
PC: Investigation, Methodology, Writing – original draft, Writing – review & editing. JC: Investigation, Methodology, Writing – original draft, Writing – review & editing. ZM: Data curation, Investigation, Writing – original draft, Writing – review & editing. HX: Data curation, Investigation, Writing – original draft, Writing – review & editing. JL: Formal Analysis, Investigation, Writing – original draft, Writing – review & editing. JW: Formal Analysis, Writing – original draft, Writing – review & editing. GX: Conceptualization, Funding acquisition, Writing – original draft, Writing – review & editing.
Funding
The author(s) declare financial support was received for the research and/or publication of this article. This work was supported by the University Collaborative Innovation Project of Anhui Province (GXXT-2023-077), the Key Projects of Scientific Research Plan of Colleges and Universities of Anhui Province (2022AH051330), the College Student Innovation and Entrepreneurship Project of Anhui Province (S202310371056), and the Biological and Medical Sciences of Applied Summit Nurturing Disciplines in Anhui Province (Anhui Education Secretary Department [2023]13).
Conflict of interest
The authors declare that the research was conducted in the absence of any commercial or financial relationships that could be construed as a potential conflict of interest.
Generative AI statement
The author(s) declare that no Generative AI was used in the creation of this manuscript.
Any alternative text (alt text) provided alongside figures in this article has been generated by Frontiers with the support of artificial intelligence and reasonable efforts have been made to ensure accuracy, including review by the authors wherever possible. If you identify any issues, please contact us.
Publisher’s note
All claims expressed in this article are solely those of the authors and do not necessarily represent those of their affiliated organizations, or those of the publisher, the editors and the reviewers. Any product that may be evaluated in this article, or claim that may be made by its manufacturer, is not guaranteed or endorsed by the publisher.
Supplementary material
The Supplementary Material for this article can be found online at: https://www.frontiersin.org/articles/10.3389/fmars.2025.1655485/full#supplementary-material
References
1
Adewoyin M. Hamarsha A. Akinsola R. Teoh S. L. Azmai M. N. A. Abu Bakar N. et al . (2024). Intraperitoneal injection of the Porphyromonas gingivalis outer membrane vesicle (OMV) stimulated expressions of neuroinflammatory markers and histopathological changes in the brains of adult zebrafish. Int. J. Mol. Sci.25, 11025. doi: 10.3390/ijms252011025
2
Ben Hamed S. Tavares Ranzani-Paiva M. J. Tachibana L. de Carla Dias D. Ishikawa C. M. Esteban M. A. (2018). Fish pathogen bacteria: Adhesion, parameters influencing virulence and interaction with host cells. Fish Shellfish Immunol.80, 550–562. doi: 10.1016/j.fsi.2018.06.053
3
Borges N. Keller-Costa T. Sanches-Fernandes G. M. M. Louvado A. Gomes N. C. M. Costa R. (2021). Bacteriome structure, function, and probiotics in fish larviculture: The good, the bad, and the gaps. Annu. Rev. Anim. Biosci.9, 423–452. doi: 10.1146/annurev-animal-062920-113114
4
Budhathoki M. Campbell D. Belton B. Newton R. Li S. Zhang W. et al . (2022). Factors influencing consumption behaviour towards aquatic food among Asian consumers: A Systematic Scoping Review. Foods11, 4043. doi: 10.3390/foods11244043
5
Cantillo Villa Y. Triga A. Katharios P. (2023). Polyinfection in fish Aeromoniasis: A study of co-isolated Aeromonas species in Aeromonas veronii outbreaks. Pathogens12, 1337. doi: 10.3390/pathogens12111337
6
Chen L. Liu C. Xiang X. Qiu W. Guo K. (2024). miR−155 promotes an inflammatory response in HaCaT cells via the IRF2BP2/KLF2/NF−κB pathway in psoriasis. Int. J. Mol. Med.54, 91. doi: 10.3892/ijmm.2024.5415
7
Chen C. Wang W. Poklis J. L. Li P. L. Lichtman A. H. Gewirtz D. A. et al . (2025). Mitigation of cisplatin-induced acute kidney injury through oral administration of fatty acid amide hydrolase inhibitor PF-04457845. J. Pharmacol. Exp. Ther.392, 100032. doi: 10.1124/jpet.124.002282
8
Chi Y. Jiao H. Ran J. Xiong C. Wei J. Ozdemir E. et al . (2023). Construction and efficacy of Aeromonas veronii mutant Δhcp as a live attenuated vaccine for the largemouth bass (Micropterus salmoides). Fish Shellfish Immunol.136, 108694. doi: 10.1016/j.fsi.2023.108694
9
Du Y. Hu X. Miao L. Chen J. (2022). Current status and development prospects of aquatic vaccines. Front. Immunol.13. doi: 10.3389/fimmu.2022.1040336
10
Dudley W. N. Benuzillo J. G. Carrico M. S. (2004). SPSS and SAS programming for the testing of mediation models. Nurs. Res.53, 59–62. doi: 10.1097/00006199-200401000-00009
11
Dutta A. Ruppert J. M. Aster J. C. Winchester E. (1993). Inhibition of DNA replication factor RPA by p53. Nature365, 79–82. doi: 10.1038/365079a0
12
Fadel A. Mabrok M. Aly S. (2018). Epizootics of Pseudomonas anguilliseptica among cultured seabream (Sparus aurata) populations: Control and treatment strategies. Microb. Pathog.121, 1–8. doi: 10.1016/j.micpath.2018.04.021
13
Felegary A. Nazarian S. Zafarmand-Samarin M. Sadeghi D. Fathi J. Samiei-Abianeh H. (2024). Evaluation of the prophylactic effect of egg yolk antibody (IgY) produced against the recombinant protein containing IpaD, IpaB, StxB, and VirG proteins from Shigella. Mol. Immunol.173, 53–60. doi: 10.1016/j.molimm.2024.07.002
14
Feng S. Y. Liang G. F. Xu Z. S. Li A. F. Du J. X. Song G. N. et al . (2018). Meta-analysis of antiviral protection of white spot syndrome virus vaccine to the shrimp. Fish Shellfish Immunol.81, 260–265. doi: 10.1016/j.fsi.2018.07.023
15
Guo K. Sun Y. Tang X. Zhou X. Jiang M. Yang Q. et al . (2023). Pathogenicity and inactivated vaccine treatment of Aeromonas veronii JW-4 on crucian carp. Microb. Pathog.183, 106315. doi: 10.1016/j.micpath.2023.106315
16
Hu B. Yang X. Guo E. Zhou P. Xu D. Qi Z. et al . (2019). The preparation and antibacterial effect of egg yolk immunoglobulin (IgY) against the outer membrane proteins of Vibrio parahaemolyticus. J. Sci. Food Agric.99, 2565–2571. doi: 10.1002/jsfa.9470
17
Jang Y. H. Subramanian D. Heo M. S. (2014). Efficacy of formalin-killed Pseudomonas anguilliseptica vaccine on immune gene expression and protection in farmed olive flounder, Paralichthys olivaceus. Vaccine32, 1808–1813. doi: 10.1016/j.vaccine.2014.01.088
18
Jiang M. Huang C. Wu Q. Su Y. Wang X. Xuan Z. et al . (2023). Sini San ameliorates CCl4-induced liver fibrosis in mice by inhibiting AKT-mediated hepatocyte apoptosis. J. Ethnopharmacol.303, 115965. doi: 10.1016/j.jep.2022.115965
19
Jomova K. Alomar S. Y. Alwasel S. H. Nepovimova E. Kuca K. Valko M. (2024). Several lines of antioxidant defense against oxidative stress: antioxidant enzymes, nanomaterials with multiple enzyme-mimicking activities, and low-molecular-weight antioxidants. Arch. Toxicol.98, 1323–1367. doi: 10.1007/s00204-024-03696-4
20
Kim H. J. Song H. K. Park S. H. Jang S. Park K. S. Song K. H. et al . (2022). Terminalia chebula Retz. extract ameliorates the symptoms of atopic dermatitis by regulating anti-inflammatory factors in vivo and suppressing STAT1/3 and NF-ĸB signaling in vitro. Phytomedicine104, 154318. doi: 10.1016/j.phymed.2022.154318
21
Kumar P. Hassan M. Tacke F. Engelmann C. (2024). Delineating the heterogeneity of senescence-induced-functional alterations in hepatocytes. Cell Mol. Life Sci.81, 200. doi: 10.1007/s00018-024-05230-2
22
Liang Z. Ning Y. Cao J. Liu S. Liang X. Peng X. et al . (2024). The protective effect of specific yolk antibody against nervous necrosis virus infection in Mandarin fish (Siniperca chuatsi). Fish Shellfish Immunol.155, 109996. doi: 10.1016/j.fsi.2024.109996
23
Liu X. Chao J. Xiao H. Chen J. Cui P. Wu X. et al . (2024a). Identification of polyvalent passive vaccine candidates from egg yolk antibodies (IgY) of important outer membrane proteins of Aeromonas hydrophila in fish. Aquacult. Rep.35, 102002. doi: 10.1016/j.aqrep.2024.102002
24
Liu X. Xiao H. Chao J. Jian S. Wu X. Lu J. et al . (2023). Polyvalent passive vaccine candidates from egg yolk antibodies (IgY) of important outer membrane proteins (PF1380 and ExbB) of Pseudomonas fluorescens in fish. Fish Shellfish Immunol.143, 109211. doi: 10.1016/j.fsi.2023.109211
25
Liu X. Xiao H. Cui P. Chen J. Chao J. Wu X. et al . (2024b). Differential polyvalent passive immune protection of egg yolk antibodies (IgY) against live and inactivated Vibrio fluvialis in fish. Fish Shellfish Immunol.151, 109751. doi: 10.1016/j.fsi.2024.109751
26
Miryala K. R. Swain B. (2025). Advances and challenges in Aeromonas hydrophila vaccine development: Immunological insights and future perspectives. Vaccines13, 202. doi: 10.3390/vaccines13020202
27
Mjølnerød E. B. Nilsen H. K. Gulla S. Riborg A. Bottolfsen K. L. Wiklund T. et al . (2021). Multilocus sequence analysis reveals different lineages of Pseudomonas anguilliseptica associated with disease in farmed lumpfish (Cyclopterus lumpus L.). PLoS One16, e0259725. doi: 10.1371/journal.pone.0259725
28
Moshrefi M. Spotin. A. Kafil H. S. Mahami-Oskouei M. Baradaran B. Ahmadpour E. et al . (2017). Tumor suppressor p53 induces apoptosis of host lymphocytes experimentally infected by Leishmania major, by activation of Bax and caspase-3: a possible survival mechanism for the parasite. Parasitol. Res.116, 2159–2166. doi: 10.1007/s00436-017-5517-8
29
Nakamura R. Pedrosa-Gerasmio I. R. Alenton R. R. R. Nozaki R. Kondo H. Hirono I. (2019). Anti-PirA-like toxin immunoglobulin (IgY) in feeds passively immunizes shrimp against acute hepatopancreatic necrosis disease. J. Fish Dis.42, 1125–1132. doi: 10.1111/jfd.13024
30
Netea M. G. Schlitzer A. Placek K. Joosten L. A. B. Schultze J. L. (2019). Innate and adaptive immune memory: An evolutionary continuum in the host’s response to pathogens. Cell Host Microbe25, 13–26. doi: 10.1016/j.chom.2018.12.006
31
Pacheco B. L. B. Nogueira C. P. Venancio E. J. (2023). IgY antibodies from birds: A review on affinity and avidity. Animals13, 3130. doi: 10.3390/ani13193130
32
Peng B. Lin X. P. Wang S. N. Yang M. J. Peng X. X. Li H. (2018). Polyvalent protective immunogens identified from outer membrane proteins of Vibrio parahaemolyticus and their induced innate immune response. Fish Shellfish Immunol.72, 104–110. doi: 10.1016/j.fsi.2017.10.046
33
Peng Y. M. Tao J. J. Kuang S. F. Jiang M. Peng X. X. Li H. (2021). Identification of polyvalent vaccine candidates from extracellular secretory proteins in Vibrio alginolyticus. Front. Immunol.12. doi: 10.3389/fimmu.2021.736360
34
Peralta R. C. Yokoyama H. Ikemori Y. Kuroki M. Kodama Y. (1994). Passive immunisation against experimental salmonellosis in mice by orally administered hen egg-yolk antibodies specific for 14-kDa fimbriae of Salmonella enteritidis. J. Med. Microbiol.41, 29–35. doi: 10.1099/00222615-41-1-29
35
Qin Z. Babu V. S. Li N. Fu T. Li J. Yi L. et al . (2018). Protective effects of chicken egg yolk immunoglobulins (IgY) against experimental Aeromonas hydrophila infection in blunt snout bream (Megalobrama amblycephala). Fish Shellfish Immunol.78, 26–34. doi: 10.1016/j.fsi.2018.04.001
36
Qin S. Xiao X. Dai Z. Zhao G. Cui Z. Wu Y. et al . (2024). Effects of Bacillus licheniformis on growth performance, immune and antioxidant functions, and intestinal microbiota of broilers. Poult. Sci.103, 103210. doi: 10.1016/j.psj.2023.103210
37
Sadat A. El-Sherbiny H. Zakaria A. Ramadan H. Awad A. (2021). Prevalence, antibiogram and virulence characterization of Vibrio isolates from fish and shellfish in Egypt: a possible zoonotic hazard to humans. J. Appl. Microbiol.131, 485–498. doi: 10.1111/jam.14929
38
Sakulworakan R. Chokmangmeepisarn P. Dinh-Hung N. Sivaramasamy E. Hirono I. Chuanchuen R. et al . (2021). Insight into whole genome of Aeromonas veronii isolated from freshwater fish by resistome analysis reveal extensively antibiotic resistant traits. Front. Microbiol.12. doi: 10.3389/fmicb.2021.733668
39
Sanahuja I. Fernández-Alacid L. Ordóñez-Grande B. Sánchez-Nuño S. Ramos A. Araujo R. M. et al . (2019). Comparison of several non-specific skin mucus immune defences in three piscine species of aquaculture interest. Fish Shellfish Immunol.89, 428–436. doi: 10.1016/j.fsi.2019.04.008
40
Sasikumar R. Saranya S. Lourdu Lincy L. Thamanna L. Chellapandi P. (2024). Genomic insights into fish pathogenic bacteria: A systems biology perspective for sustainable aquaculture. Fish Shellfish Immunol.154, 109978. doi: 10.1016/j.fsi.2024.109978
41
Shoushtari M. Shooshtari A. B. Asadi S. Karami Y. Honari M. Alizadeh G. A. et al . (2023). Production of egg yolk antibody (IgY) against Vibrio Cholerae O1: Protective effect in mice. Avicenna. J. Med. Biotechnol.15, 239–244. doi: 10.18502/ajmb.v15i4.13497
42
Sun Y. Hao Y. Wang Z. Wang H. Gao Y. (2024). Isolation, characterization, and whole genome sequencing analysis of Aeromonas veronii from Channa argus in China. Vet. Res. Commun.49, 7. doi: 10.1007/s11259-024-10594-8
43
Tan W. C. C. Nerurkar S. N. Cai H. Y. Ng H. H. M. Wu D. Wee Y. T. F. et al . (2020). Overview of multiplex immunohistochemistry/immunofluorescence techniques in the era of cancer immunotherapy. Cancer Commun. (Lond)40, 135–153. doi: 10.1002/cac2.12023
44
Thomsen K. Christophersen L. Jensen PØ. Bjarnsholt T. Moser C. Høiby N. (2016). Anti-Pseudomonas aeruginosa IgY antibodies promote bacterial opsonization and augment the phagocytic activity of polymorphonuclear neutrophils. Hum. Vaccin. Immunother.12, 1690–1699. doi: 10.1080/21645515.2016.1145848
45
Wang H. Zhong Q. Lin J. (2023). Egg yolk antibody for passive immunization: Status, challenges, and prospects. J. Agric. Food Chem.71, 5053–5061. doi: 10.1021/acs.jafc.2c09180
46
Wu C. J. Wang H. Chan Y. L. Li T. L. (2011). Passive immune-protection of small abalone against Vibrio alginolyticus infection by anti-Vibrio IgY-encapsulated feed. Fish Shellfish Immunol.30, 1042–1048. doi: 10.1016/j.fsi.2011.01.026
47
Xiao H. Chen J. Cui P. Che X. Wu X. Lu J. et al . (2025a). Evaluation of the multivalent immunoprotective effects of protein, DNA, and IgY vaccines against Vibrio fluvialis outer membrane protein VF14355 in Carassius auratus. Int. J. Mol. Sci.26, 3379. doi: 10.3390/ijms26073379
48
Xiao H. Cui P. Chen J. Han X. Ma Z. Chen C. et al . (2024). A comparison of polyvalent passive immunoprotection from antibodies with different immunity models of live or inactivated Vibrio fluvialis in fish. Fishes9, 302. doi: 10.3390/fishes9080302
49
Xiao H. Duan S. Cui P. Chen J. Che X. Lu J. et al . (2025b). Polyvalent immunoprotection of protein, DNA and IgY antibody vaccines of Vibrio fluvialis outer membrane protein VF08100 in fish. Fish Shellfish Immunol.161, 110260. doi: 10.1016/j.fsi.2025.110260
50
Xu Y. Li C. Yin H. Nowsheen S. Xu X. Kang W. et al . (2024). STK39-mediated amplification of γ-H2A.X promotes homologous recombination and contributes to PARP inhibitor resistance. Nucleic Acids Res.52, 13881–13895. doi: 10.1093/nar/gkae1099
51
Zhang L. Bai Y. Tao J. Yang S. Tu C. Liu L. et al . (2024a). Effects of feeding chicken egg yolk antibodies on intestinal cell apoptosis, oxidative stress and microbial flora of tilapia (Oreochromis niloticus) infected with Streptococcus agalactiae. Fish Shellfish Immunol.150, 109596. doi: 10.1016/j.fsi.2024.109596
52
Zhang Z. Li X. Huang M. Huang Y. Tan X. Dong Y. et al . (2024b). Siglec7 functions as an inhibitory receptor of non-specific cytotoxic cells and can regulate the innate immune responses in a primitive vertebrate (Oreochromis niloticus). Int. J. Biol. Macromol.278, 134851. doi: 10.1016/j.ijbiomac.2024.134851
53
Zhao K. Gaines S. D. García Molinos J. Zhang M. Xu J. (2024). Effect of trade on global aquatic food consumption patterns. Nat. Commun.15, 1412. doi: 10.1038/s41467-024-45556-w
54
Zhong X. Zhang S. Wang H. Yang J. Li L. Zhu J. et al . (2022). Ultrasound-alkaline combined extraction improves the release of bound polyphenols from pitahaya (Hylocereus undatus ‘Foo-Lon’) peel: Composition, antioxidant activities and enzyme inhibitory activity. Ultrason. Sonochem.90, 106213. doi: 10.1016/j.ultsonch.2022.106213
Summary
Keywords
Pseudomonas anguilliseptica , multivalent vaccine, IgY antibody, passive immunity, aquaculture
Citation
Cui P, Chen J, Ma Z, Xiao H, Lu J, Wang J and Xu G (2025) The multivalent passive immune-protective vaccines of egg yolk immunoglobulin Y derived from live or inactivated Pseudomonas anguilliseptica against aquaculture pathogens (P. anguilliseptica and Aeromonas veronii) in goldfish (Carassius auratus). Front. Mar. Sci. 12:1655485. doi: 10.3389/fmars.2025.1655485
Received
01 July 2025
Accepted
22 August 2025
Published
12 September 2025
Volume
12 - 2025
Edited by
Ji Hyung Kim, Gachon University, Republic of Korea
Reviewed by
Sang Wha Kim, Kangwon National University, Republic of Korea
Yucong Huang, Guangdong Ocean University, China
Updates
Copyright
© 2025 Cui, Chen, Ma, Xiao, Lu, Wang and Xu.
This is an open-access article distributed under the terms of the Creative Commons Attribution License (CC BY). The use, distribution or reproduction in other forums is permitted, provided the original author(s) and the copyright owner(s) are credited and that the original publication in this journal is cited, in accordance with accepted academic practice. No use, distribution or reproduction is permitted which does not comply with these terms.
*Correspondence: Gaoxiao Xu, xgx138@126.com
Disclaimer
All claims expressed in this article are solely those of the authors and do not necessarily represent those of their affiliated organizations, or those of the publisher, the editors and the reviewers. Any product that may be evaluated in this article or claim that may be made by its manufacturer is not guaranteed or endorsed by the publisher.